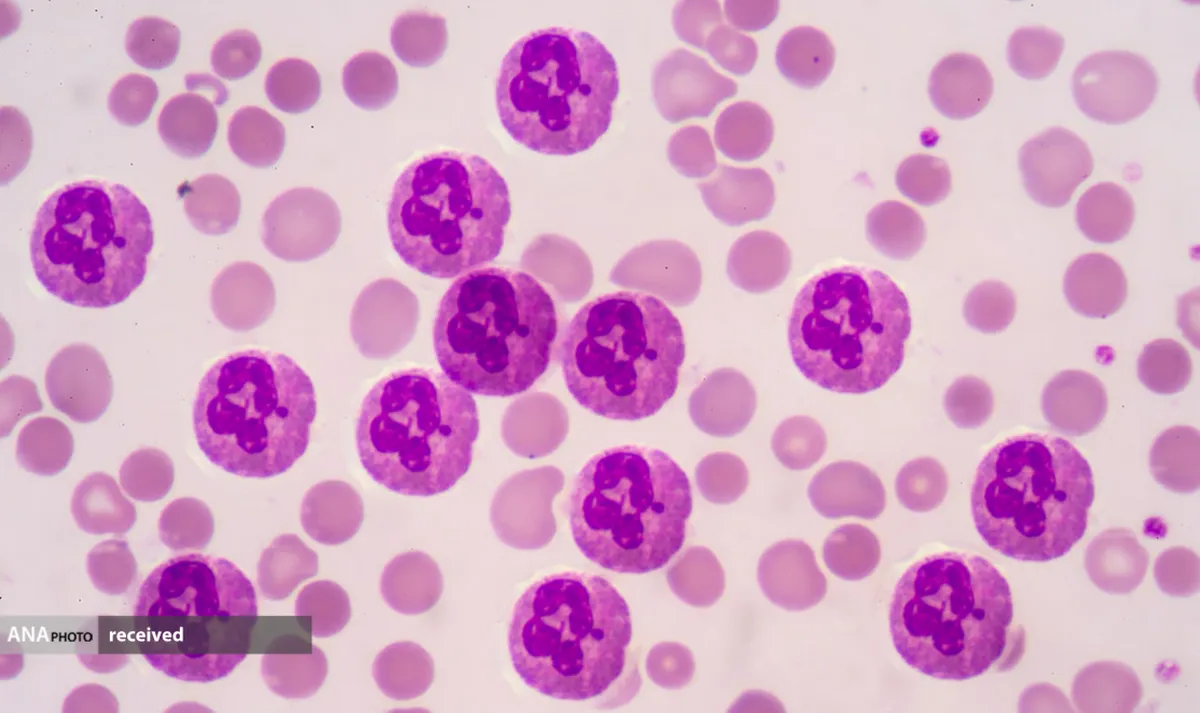

مواد شیمیایی سمی عملکرد حیاتی سلولهای ایمنی را مختل میکند
به گزارش خبرنگار گروه دانش و فناوری خبرگزاری آنا، اثرات منفی مواد شیمیایی به نام PFAS بر سلامتی همچنان آشکار است. اکنون دانشمندان دانشگاه ایالتی کارولینای شمالی (NCSU) نشان دادهاند که برخی از انواع PFAS میتوانند عملکرد حیاتی سلولهای ایمنی را مختل کنند.
مواد پر و پلی فلوروآلکیل (PFAS) گروه وسیعی از مواد شیمیایی هستند که هر چه تحقیقات بیشتری روی آنها انجام شود مشکل سازتر میشوند. از آنجایی که آنها در دهه ۱۹۴۰ ساخته شدند، خاصیت نچسب و دفع آب آنها آنها را برای طیف وسیعی از مصارف در محصولات معمولی خانگی جذاب کرد، اما مدتی بعد تأثیرات سلامتی آنها آشکار شد. قرار گرفتن در معرض PFAS با دیابت، وزن کم هنگام تولد، مشکلات باروری، بیماری تیروئید و سرطانهای مختلف و موارد دیگر مرتبط است. بدتر از آن، عمر طولانی و فراوانی این مواد، اجتناب از قرار گرفتن در معرض آنها را دشوار میکند.
سیستم ایمنی انسان دارای دو شاخه است: تطبیقی و ذاتی. شاخه تطبیقی شامل سلولهای T و سلولهای B است که پاتوژنهایی را که بدن با آنها مواجه شده است «به یاد میآورند»، اما به کندی دفاع میکند، و این فرایند روزها وگاهی هفتهها پس از شناسایی یک عامل بیماریزا اتفاق می افتد.سیستم ایمنی ذاتی به عنوان اولین پاسخ دهنده بدن عمل میکند و حاوی گلبولهای سفید خون است که میتوانند در عرض چند ساعت به محل تهاجم فرستاده شوند. این گلبولهای سفید شامل نوتروفیلها هستند که میتوانند گونههای فعال اکسیژن را رها کنند(مقادیر کمی سفیدکننده یا پراکسید هیدروژن فکر کنید که نوتروفیلها در داخل سلولهای خود تولید میکنند) مستقیماً روی پاتوژنها ریخته و آنها را میکشند. این فرآیند انفجار تنفسی نامیده میشود.
در مطالعه جدید، محققان اثرات ۹ مولکول مختلف PFAS را بر روی سیستم ایمنی ذاتی که قبلاً به خوبی مطالعه نشده بود، بررسی کردند. این تیم PFAS را روی سلولهای ایمنی به نام نوتروفیلها (برخی از اولین واکنشدهندههای بدن به عفونت) آزمایش کردند که با ریختن گونههای اکسیژن فعال روی پاتوژنها در فرآیندی به نام انفجار تنفسی مبارزه میکنند.
در این پژوهش سه گروه از نوتروفیلها مورد آزمایش قرار گرفتند: برخی از نمونههای خون انسان، برخی از جنینهای گورخرماهی و برخی دیگر از سلولهایی که تحت درمان شیمیایی قرار گرفته بودند تا مانند نوتروفیلها رفتار کنند. هر گروه در معرض محلولهایی از ۹ ماده شیمیایی PFAS قرار گرفتند که همگی در رودخانه کیپ فیر در کارولینای شمالی و همچنین خون مردم منطقه شناسایی شدهاند.
یکی از PFAS دردسرسازتر از بقیه بود_ «GenX»، یک ماده شیمیایی که برای جایگزینی PFAS سمیتر معرفی شد، اما در نهایت دانشمندان متوجه شدند که این ماده هم نگرانیهای سلامتی خودش را دارد. در این مورد مشخص شد که GenX فرآیند انفجار تنفسی را در هر سه گروه مختل میکند و به طور بالقوه پاسخ ایمنی به عوامل بیماری زا را تضعیف میکند. PFAS دوم به نام «PFHxA» نیز برای سرکوب این فرآیند یافت شد، اما فقط در گورخرماهی و سلولهای شبه نوتروفیل.
محققان میگویند که این مطالعه نگرانیهای جدیدی را در مورد این مواد شیمیایی مشکلساز آشکار میکند، اما کار بیشتری باید انجام شود تا بررسی شود که این مواد چگونه ممکن است بر سیستم ایمنی ذاتی در سطوحی که افراد روزمره در معرض آن قرار میگیرند، تأثیر بگذارند.
جف یودر، نویسنده و مسئول این مطالعه میگوید: «طولانیترین قرار گرفتن در معرض مواد شیمیایی در مطالعه ما چهار روز بود، بنابراین واضح است که ما نمیتوانیم آن را با قرار گرفتن واقعی انسان در معرض این ماده در طول چهار دهه مقایسه کنیم. " ما دوز بالایی از PFAS منفرد را در یک دوره کوتاه بررسی کردیم، در حالی که مردم در حوضه رودخانه کیپ فیر در معرض مخلوطی از PFAS قرار گرفتند (دوز پایین در یک دوره طولانی) بنابراین، در حالی که میتوانیم بگوییم که یک اثر سمی از دوز بالا در ردههای سلولی میبینیم، هنوز نمیتوانیم بگوییم که قرار گرفتن در معرض طولانیمدت در نهایت چه تأثیری بر سیستم ایمنی دارد.»
این تحقیق در مجله Immunotoxicology منتشر شده است.
انتهای پیام/
- تور استانبول
- غذای سازمانی
- خرید کارت پستال
- لوازم یدکی تویوتا قطعات تویوتا
- مشاوره حقوقی
- تبلیغات در گوگل
- بهترین کارگزاری بورس
- ثبت نام آمارکتس
- سایت رسمی خرید فالوور اینستاگرام همراه با تحویل سریع
- یخچال فریزر اسنوا
- گاوصندوق خانگی
- تاریخچه پلاک بیمه دات کام
- ملودی 98
- خرید سرور اختصاصی ایران
- بلیط قطار مشهد
- رزرو بلیط هواپیما
- ال بانک
- آهنگ جدید
- بهترین جراح بینی ترمیمی در تهران
- اهنگ جدید
- خرید قهوه
- اخبار بورس
























